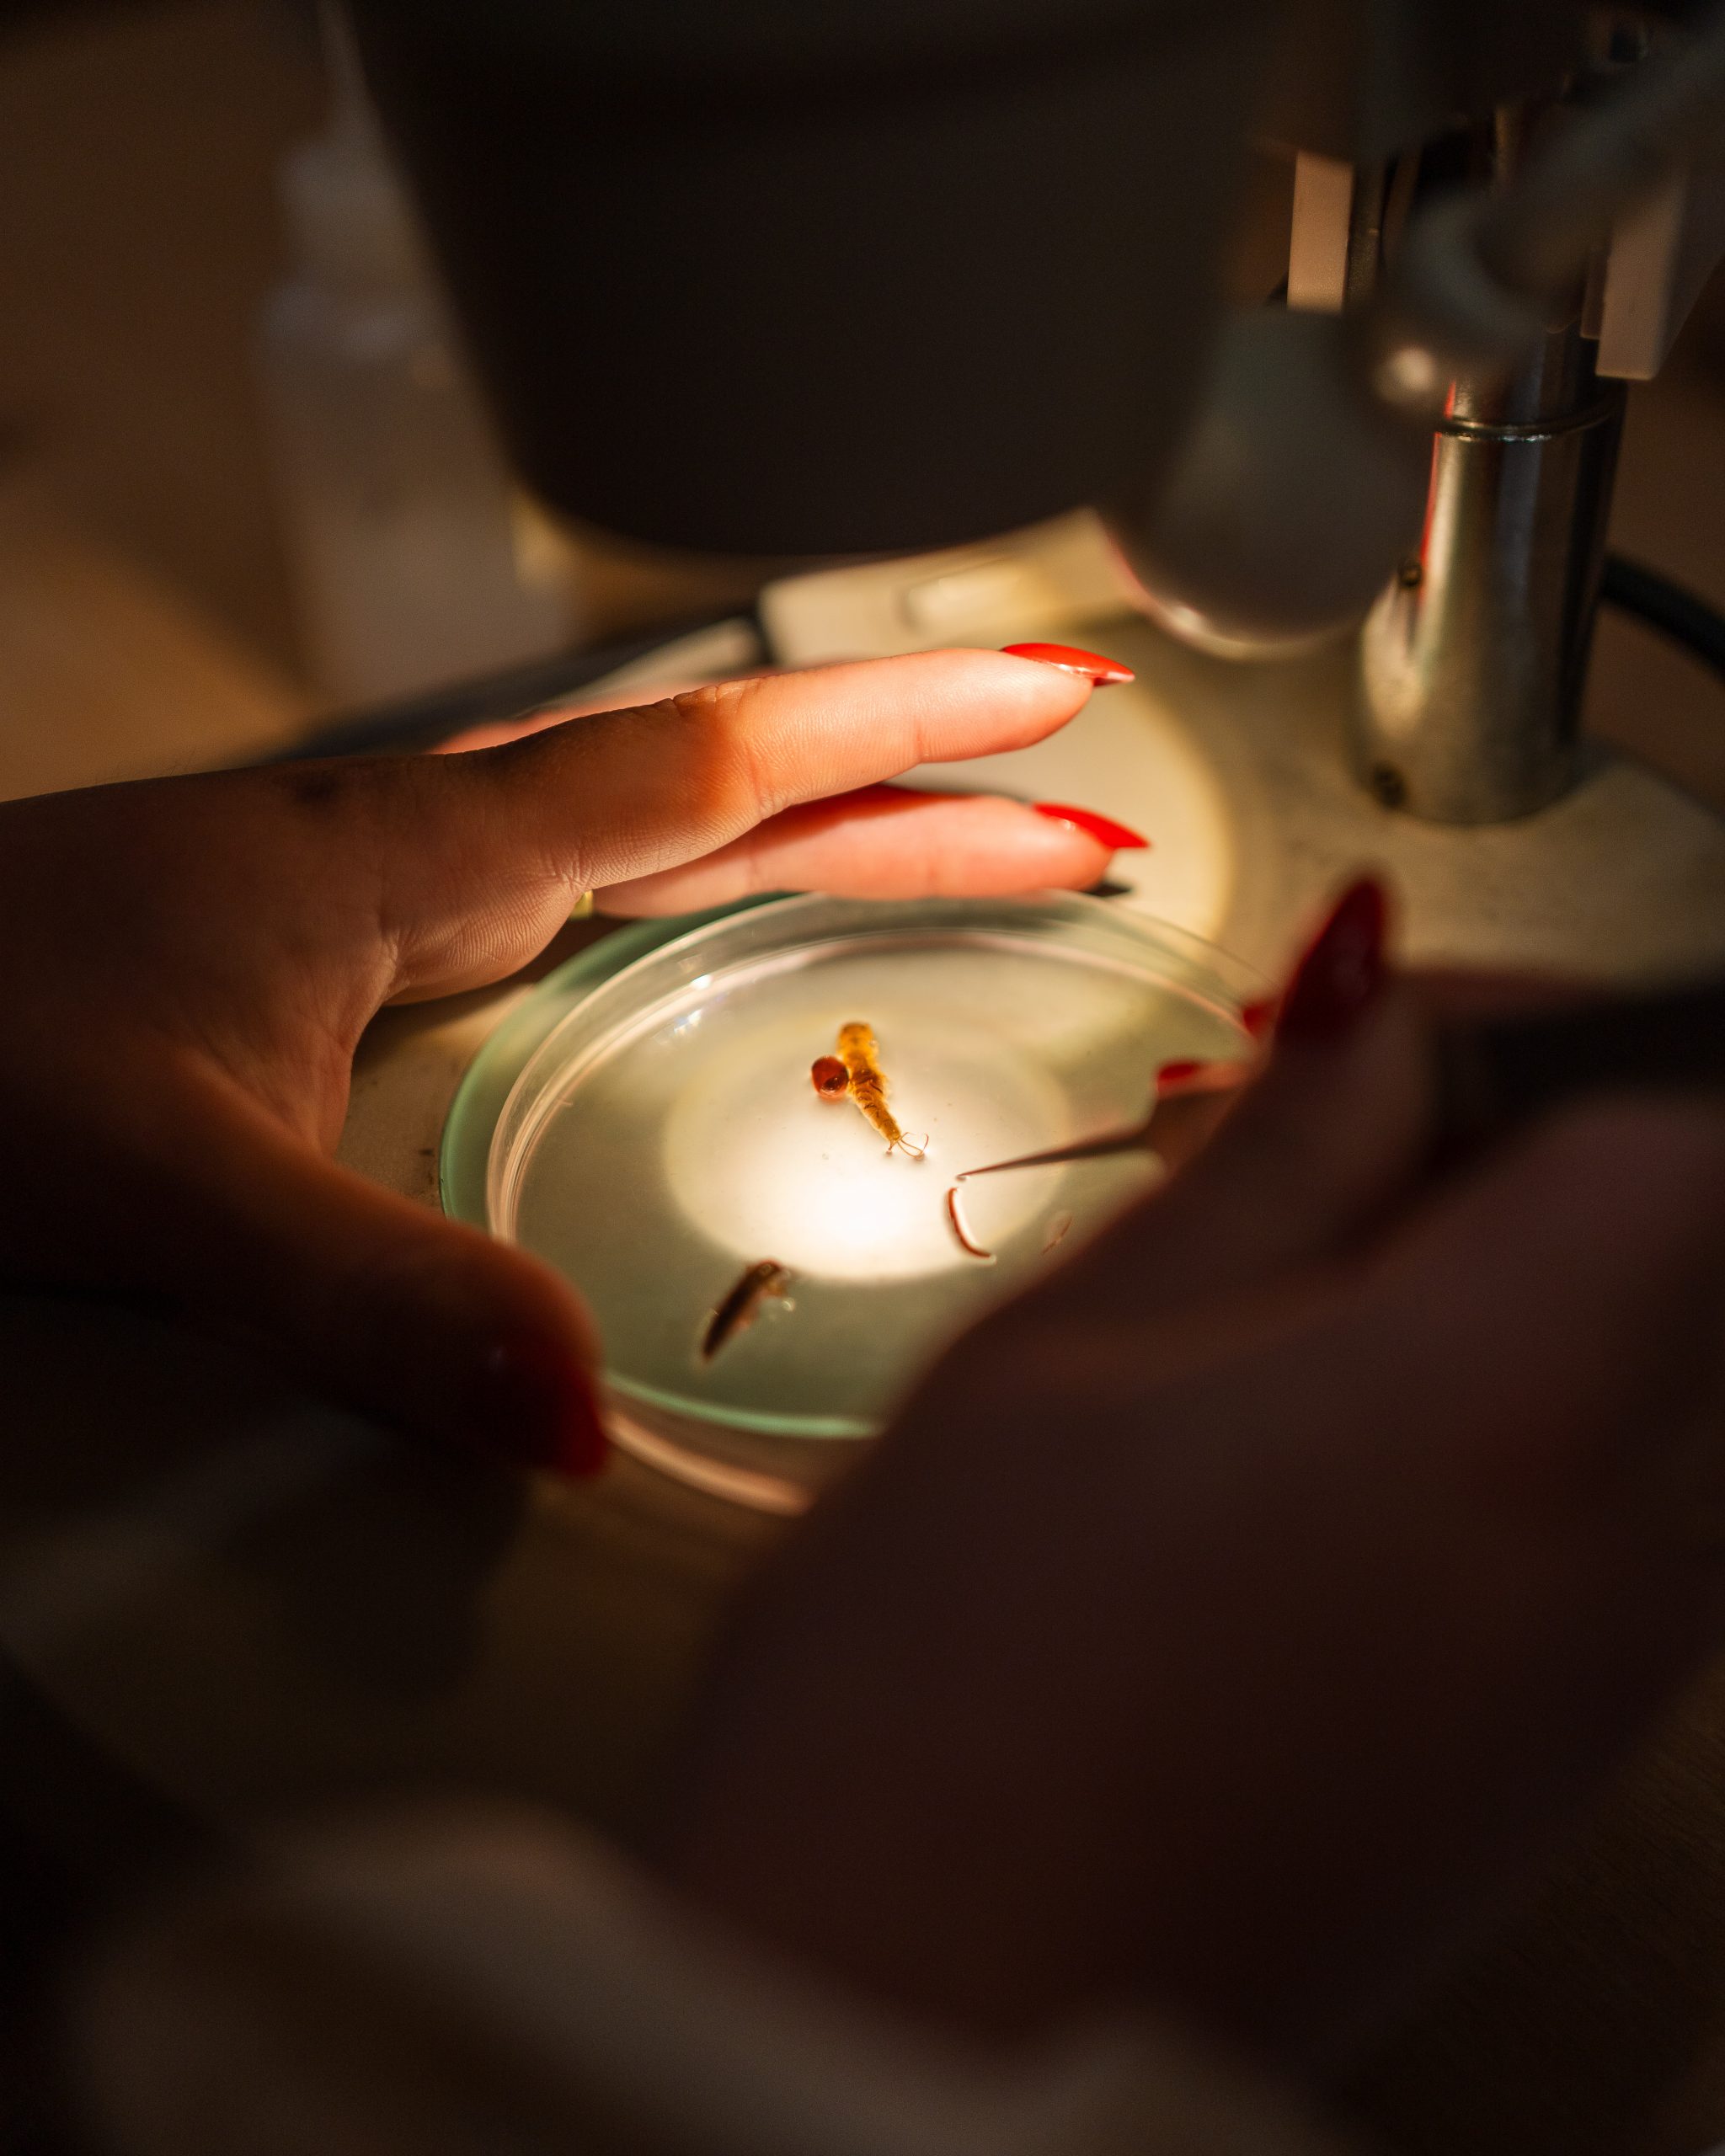

Des mesures et inventaires Faune et Flore ou les simples analyses qualitatives, jusqu’à l’étude d’impact complète
Du diagnostic de vos infrastructures à la définition des besoins pour l’amélioration de leur fonctionnement
De l’élaboration de votre projet :
Au suivi de la bonne exécution de vos travaux

Notre équipe réunit des spécialistes des principaux domaines de l’environnement, reconnus pour leur expertise pointue et leur maîtrise des outils spécifiques à leur secteur, tels que la modélisation, le DAO et les SIG.
Parce que chaque projet est unique et que son aboutissement résulte de la maîtrise d’interactions complexes, en particulier lorsqu’ils sont innovants (nos préférés), nous avons développé une méthodologie spécifique avec une approche interdisciplinaire.

Dossiers d’études et projets
Engagés et à votre écoute pour votre satisfaction
Des honoraires ajustés aux enjeux de votre problématiques





















